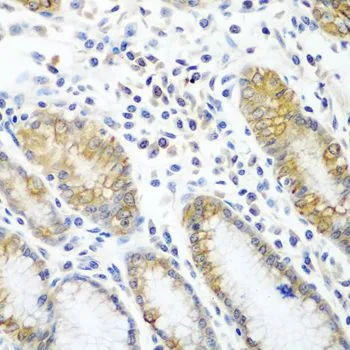

IHC-P analysis of human stomach tissue using GTX32458 ATAD3A antibody. Dilution : 1:100
ATAD3A antibody
GTX32458
ApplicationsWestern Blot, ImmunoHistoChemistry, ImmunoHistoChemistry Paraffin
Product group Antibodies
ReactivityHuman, Mouse
TargetATAD3A
Overview
- SupplierGeneTex
- Product NameATAD3A antibody
- Delivery Days Customer9
- Application Supplier NoteWB: 1:500 - 1:2000. IHC-P: 1:100 - 1:200. *Optimal dilutions/concentrations should be determined by the researcher.Not tested in other applications.
- ApplicationsWestern Blot, ImmunoHistoChemistry, ImmunoHistoChemistry Paraffin
- CertificationResearch Use Only
- ClonalityPolyclonal
- ConjugateUnconjugated
- Gene ID55210
- Target nameATAD3A
- Target descriptionATPase family AAA domain containing 3A
- Target synonymsHAYOS, PHRINL, ATPase family AAA domain-containing protein 3A
- HostRabbit
- IsotypeIgG
- Protein IDQ9NVI7
- Protein NameATPase family AAA domain-containing protein 3A
- Scientific DescriptionThis gene encodes a ubiquitously expressed mitochondrial membrane protein that contributes to mitochondrial dynamics, nucleoid organization, protein translation, cell growth, and cholesterol metabolism. This gene is a member of the ATPase family AAA-domain containing 3 gene family which, in humans, includes two other paralogs. Naturally occurring mutations in this gene are associated with distinct neurological syndromes including Harel-Yoon syndrome. High-level expression of this gene is associated with poor survival in breast cancer patients. A homozygous knockout of the orthologous gene in mice results in embryonic lethality at day 7.5 due to growth retardation and defective development of the trophoblast lineage. Alternative splicing results in multiple transcript variants. [provided by RefSeq, Feb 2017]
- ReactivityHuman, Mouse
- Storage Instruction-20°C or -80°C,2°C to 8°C
- UNSPSC41116161







